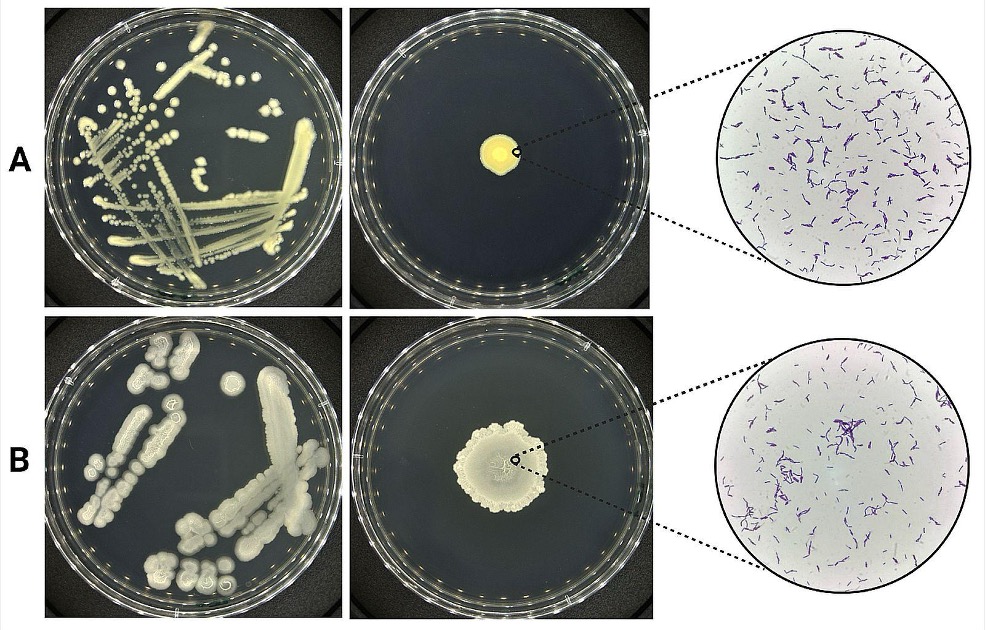

SciEnggJ. 2025 18 (2) 264-274
available online: 14 August 2025
DOI: https://doi.org/10.54645/2025182JXP-97
*Corresponding author
Email Address: rmmanalo4@up.edu.ph
Date received: 28 April 2025
Dates revised: 18 July 2025
Date accepted: 29 July 2025
Mangrove soil-derived Bacillus sp. strain IPS8 exhibits anticandidal potential
The unmet research need and the increasing public health threat of Candida infections warrant the search for sources of novel anticandidal agents. The present study isolated and screened mangrove soil-derived bacteria for anticandidal activity against C. albicans, C. glabrata, and C. tropicalis. Six bacteria were isolated from the mangrove forest subsoils of Alabat Island, Quezon Province, Philippines. Two of these bacteria, namely strains IPS7 and IPS8, showed antagonistic activities via the cross-streak and agar plug methods. However, only the cell-free culture supernatant (CFCS) containing the bacterial metabolites of IPS8 showed inhibitory capacity against C. albicans and C. tropicalis in the agar well diffusion assay. Interestingly, the activity of the IPS8 CFCS was not statistically different from the activity of amphotericin B against C. albicans (p = 0.05267). Based on the combined morphological, biochemical, and genomic data, the strain IPS8 was putatively identified as Bacillus velezensis. The results of this study demonstrate that mangrove soil-derived bacteria, such as strain IPS8, are potential sources of anticandidal agents.
© 2026 SciEnggJ
Philippine-American Academy of Science and Engineering